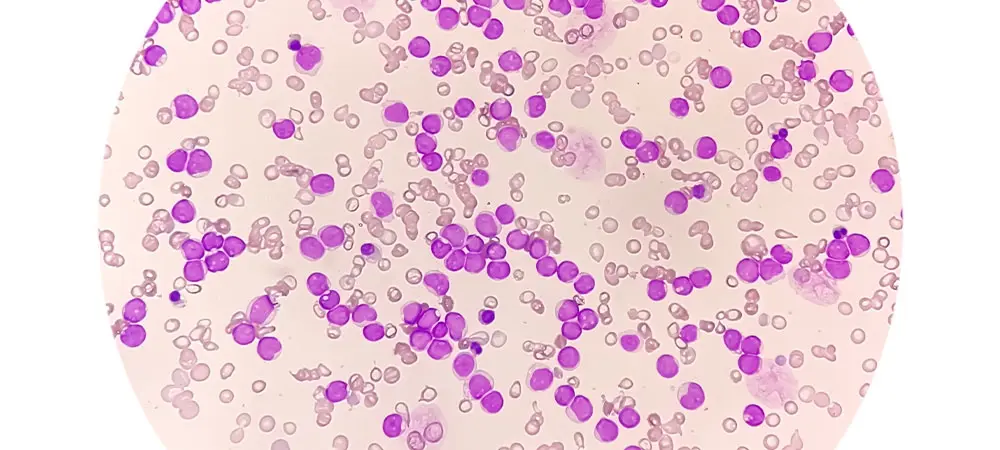
entry image

Lenfosit nedir? LYM düşüklüğü/ yüksekliği neden olur?
Lenfositler, beyaz kan hücreleridir ve T, B ve doğal öldürücü hücreleri içerir. Bu hücreler antikor üretimi, virüsle enfekte olmuş ve tümörlü hücrelerin doğrudan hücre aracılı öldürülmesi ve bağışıklık tepkisinin düzenlenmesinden sorumludur. Kandaki yüksek lenfosit seviyelerine lenfositoz denir. Lenfositoz genellikle bir enfeksiyon veya hastalıktan kaynaklanır. Kandaki düşük lenfosit seviyelerine lenfositopeni (veya lenfopeni) denir. Düşük lenfositi varsa, enfeksiyon riski daha yüksektir. Grip veya diğer hafif enfeksiyonlar lenfositopeniye neden olabilir, ancak daha ciddi bir hastalık veya durum da buna neden olabilir.
Lenfosit (LYM) nedir?
Lenfosit (LYM) beyaz kan hücresi türüdür ve bağışıklık sisteminin bir parçasıdır. Viral enfeksiyonlarla savaşmaya yardımcı olurlar ve vücudun enfekte hücreleri veya tümör hücrelerini yok etmesine yardımcı olurlar. Beyaz kan hücrelerinin yaklaşık %20-40'ı lenfositlerdir. Lenfosit seviyeleri yaş, ırk, cinsiyet ve yaşam tarzınıza bağlı olarak değişir.
İki ana lenfosit türü vardır:
T lenfositleri (T hücreleri)
T hücreleri vücudun bağışıklık sistemi tepkisini kontrol eder ve doğrudan enfekte hücrelere ve tümör hücrelerine saldırır ve onları öldürür.
B lenfositleri (B hücreleri)
B hücreleri antikor üretir. Antikorlar virüsleri, bakterileri ve diğer yabancı istilacıları hedef alan proteinlerdir.
Lenfosit kaç olmalı?
Yetişkinlerde, lenfositlerin normal aralığı her 1 mikrolitre kanda 1.000 ila 4.800 lenfosit arasındadır. Çocuklarda, lenfositlerin normal aralığı her 1 mikrolitre kanda 3.000 ila 9.500 lenfosit arasındadır.
Lenfosit yüksek çıkması ne demek?
Testte yüksek lenfosit seviyeleri lenfositoz olarak adlandırılır. Bu, bir enfeksiyon veya hastalık nedeniyle olabilir. Vücudunuz bu enfeksiyon veya hastalıkla savaşmaya yardımcı olmak için ekstra lenfosit üretebilir. Ancak yüksek lenfosit seviyelerine neden olan ciddi bir rahatsızlığınız olabilir, örneğin:
Hepatit.
Frengi.
Mononükleoz.
HIV veya AIDS.
Tüberküloz (Verem).
Tiroid bezinin az çalışması.
Boğmaca, toksoplazmoz, sitomegalovirüs veya diğer enfeksiyonlar.
Lenfoma, lösemi veya diğer kan kanserleri.
LYM yüksekliği tehlikeli mi?
Lenfosit seviyeleriniz yüksekse, bağışıklık sisteminiz hastalık veya rahatsızlıkla savaşıyor olabilir. Çoğunlukla zararsızdır ve uzun sürmez. Ancak yüksek seviyeler, kan kanseri veya kronik enfeksiyon gibi daha ciddi bir şeyin sonucu olabilir.
Lenfosit yüksekliği nasıl tedavi edilir?
Lenfosit yüksekliğinin yani lenfositozun genellikle ciddi semptomları yoktur. Lenfositoz ciddi bir hastalıktan kaynaklanıyorsa bazı semptomlar olabilir. Bu semptomlar boyun bölgesindeki, koltuk altlarındaki ve midenizin yakınındaki lenf düğümlerinde şişliktir. Diğer semptomlar arasında nefes darlığı, şiddetli ağrı, ateş, gece terlemeleri, iştahsızlık, yorgunluk, enfeksiyon, mide bulantısı, kusma vb. bulunur.
Lenfositoz vakalarının çoğu, hastalığın birincil nedeni olabilen altta yatan hastalığın tedavisiyle iyileşir. Kanser de lenfositoza neden olabilir. Bu gibi durumlarda doktorlar kemoterapi önerir. Genellikle, birden fazla ilaç kullanılır veya etkilenen hücreleri hedef alan bir ilaç kombinasyonu kullanılır. Kemoterapi genellikle üç ila dört haftalık döngülerde yapılır. Süre, ciddiyete bağlı olarak uzatılabilir. Haftalar arasındaki boşluk, hücrelerin iyileşmesine ve onarılmasına izin vermek içindir. Ateş, mide bulantısı, düşük kan sayımı vb. gibi bazı yan etkiler olabilir.
İmmünoterapi, şiddetli lenfositoz vakalarını tedavi etmek için kullanılan bir diğer karmaşık prosedürdür. İmmünoterapide, ilaçlar bağışıklık sisteminizin hücreleri tanımlamasına ve bu hücreleri yok etmesine yardımcı olmak için kullanılır.
Diğer tedavi biçimleri arasında hedefli hücre tedavisi, kök hücre tedavisi vb. yer alır. Bu tedaviler genellikle şiddetli lenfositoz vakalarını tedavi etmek için kullanılır.
Lenfosit düşüklüğü neden olur?
Kanınızdaki lenfosit seviyelerinin düşük olmasına lenfopeni veya lenfositopeni denir. Lenfosit düşüklüğüne grip veya diğer hafif enfeksiyonlar neden olabilir, ancak daha ciddi bir durumdan da kaynaklanabilir, örneğin:
HIV veya AIDS.
Tüberküloz.
Tifo ateşi.
Viral hepatit.
Hodgkin hastalığı veya diğer kan hastalıkları.
Lupus veya diğer otoimmün hastalıklar.
Şiddetli kombine immün yetmezlik, ataksi-telenjiektazi, DiGeorge sendromu, Wiskott-Aldrich sendromu veya başka nadir kalıtsal hastalık.
Radyasyon.
Kemoterapi.
Lenfosit düşüklüğü tedavisi
Lenfopenisi olan kişilerin asemptomatik olması, yani semptom yaşamaması yaygındır. Ancak, bir kişi sık sık soğuk algınlığı veya zatürre geçiriyorsa veya alışılmadık enfeksiyonlar geliştiriyorsa, bu düşük lenfositlere işaret ediyor olabilir.
Lenfositopeninin belirtileri şunlardır:
Ateş.
Öksürük.
Burun akması.
Döküntü veya diğer cilt tahrişleri.
Şişmiş lenf düğümleri.
Eklem şişlikleri.
Ağız ülserleri.
Sarılık.
Dalak büyümesi (splenomegali).
Şiddetli lenfopenide sık enfeksiyonlar yaşayabilir veya uzun süren enfeksiyonlar yaşayabilirsiniz.
Hafif lenfositopeni formları genellikle tedavi gerektirmez çünkü vücudunuz enfeksiyondan kurtulduktan sonra lenfosit seviyeleri normale dönecektir. Diğer durumlarda tedaviye ihtiyaç duyulabilir. Tedavi altta yatan rahatsızlığa odaklanır. Doktorunuz, düşük seviyelerin nedenine bağlı olarak tedaviler önerebilir.
Vücudun yeterli lenfosit üretmesini engelleyen bir rahatsızlıkla doğan kişilerde, hematopoietik kök hücre nakli potansiyel bir tedavi olabilir. Bu yöntem, hasarlı veya kusurlu kan oluşturan kan hücrelerini (kök hücreler) sağlıklı kök hücrelerle değiştirir. Kök hücreler sonunda lenfositler de dahil olmak üzere tamamen olgun kan hücrelerine dönüşür. Kök hücre nakli riskleri olan bir prosedür olduğu için doktorunuzun buna uygun olup olmadığınızı söylemesi gereklidir.
Eğer şiddetli lenfopeni varsa immünoglobulin (IG) aşıları kullanılabilir. Bu tedavi bağışıklık sisteminizi güçlendirebilir, böylece enfeksiyonlarla daha iyi savaşabilir.







































